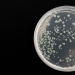
Los científicos quieren diseñar bacterias para la sostenibilidad de la minería de tierras raras

Newcrest Mining (ASX: NCM; TSX: NCM; PNGX: NCM), con sede en Australia, está construyendo una masa crítica en Canadá con la segunda adquisición importante anunciada a medida que la importante empresa minera apunta al crecimiento orgánico y basado en fusiones y adquisiciones en las Américas. el director gerente y CEO Sandeep Biswas le dice a The Northern Miner.
En 300, Newcrest adquirió una participación del 70% en la mina de cobre y oro Red Chris de Imperial Metals (TSX: III) en el norte Columbia Británica y, más recientemente, la adquisición de Pretium Resources por $2.800 millones, anunciada el 9 de noviembre, para obtener el control de su operación Brucejack de alto grado en Columbia Británica.
“Newcrest se especializa en lo que yo llamo depósitos de primer nivel”, dice Biswas en una entrevista. “Tenemos una estrategia clara en la que queremos seguir ganando exposición a los depósitos de primer nivel, que en nuestra terminología suele ser 300, 000-más el equivalente en onzas por año que comprende cobre, si está disponible, y oro.”
Además, la empresa tiene una inclinación por los activos de larga duración, por lo general 15 años o más, y los activos también deben ser de bajo costo con la capacidad de entrar en el rango del primer cuartil. , según Biswas.
“Si miras a Brucejack, cumple con todos los criterios. Y también está en una jurisdicción de primer nivel, lo que nos brinda cierta dispersión geográfica y también reduce el riesgo geográfico”.
(Seguir leyendo en El minero del norte)